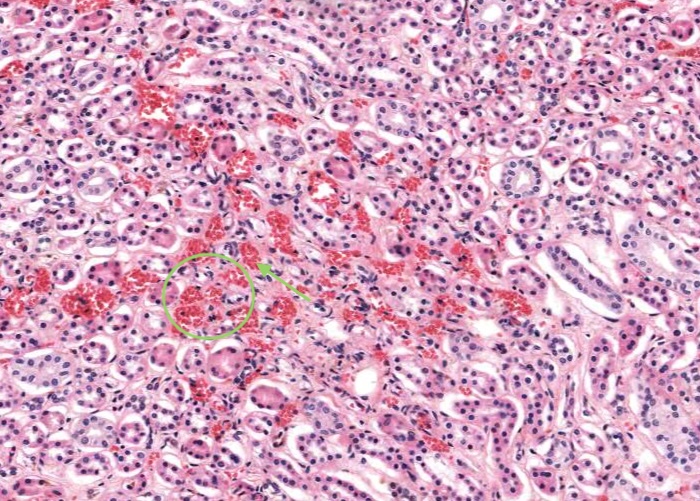
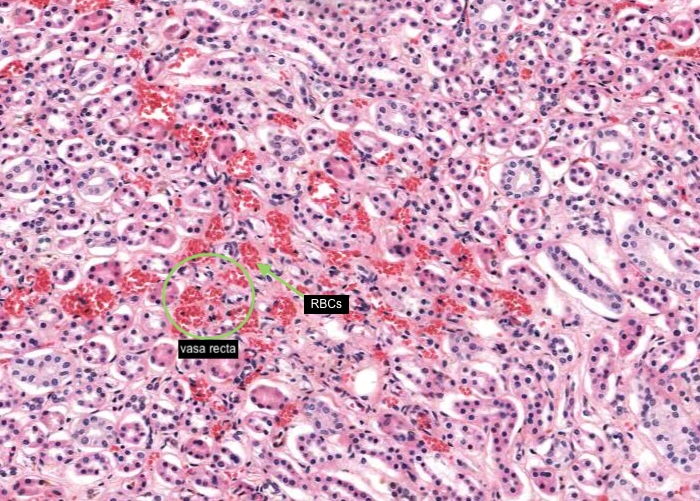

1/44
Looks like no tags are added yet.
Name | Mastery | Learn | Test | Matching | Spaced | Call with Kai |
|---|
No analytics yet
Send a link to your students to track their progress
The urinary system consists of the paired kidneys, paired ureters, urinary bladder and the urethra. This system has numerous specific functional roles centred on conserving essential components of the blood and extracellular/body fluids - and eliminating wastes.
Learning outcomes
After studying this module, you should be able to
recognize the following gross structures of the kidney:
pyramid.
lobe.
major and minor calyx.
distinguish the medulla from the cortex.
renal pelvis and ureter.
renal papilla.
major arteries and veins supplying and draining the kidney.
recognize and define a lobule.
define and describe a uriniferous tubule, a nephron, and a renal corpuscle.
know the structure and function of the glomerulus and the filtration apparatus.
identify and understand the general functions of the proximal convoluted tubule, the loop of Henle, the distal convoluted tubule and the collecting ducts.
recognise a macula densa and understand the function of the juxtaglomerular apparatus.
understand the functioning of the renin-angiotensin-aldosterone-ADH system.
understand the blood supply to the kidney and to the nephron.
recognise the vasa recta and understand their origin.
differentiate between the cortical and juxtamedullary nephrons and understand the special function of the latter.
know the general functions of the ureter, bladder and the male and female urethra.
Knowledge of the anatomical structure of the kidney is very important so study this image carefully and make sure you are very familiar with the structures labellel 1-15.

capsule
cortex
medulla
renal papilla
minor calyx
hilum
renal artery
renal corpuscle

Kidneys of small animals consist of only a single lobe. An image of a section across the whole kidney of a small monkey is provided here. Locate the major gross divisions of the kidney: capsule, a darker pink/crimson stained outer region - cortex, a paler central region - medulla, and the renal pyramid with the apical portion (renal papilla) projecting into the minor calyx. The hilum is where renal vessels enter e.g. renal artery (or leave, in the case of the renal vein) and is continuus with the renal pelvis where the ureter begins. Each tiny dot you see within the cortex is a renal corpuscle.
Note: This is the histological section you will view using virtual microscopy to see most of the structural characteristics listed in the items that follow for the "Kidney" and so you need to make sure you can readily identify these major subdivisions of the kidney - particulary the kidney cortex and medulla.


You will know where to locate the kidney capsule from the previous item of a section through a kidney lobule but now you can see details of the structure of this capsule in this image taken at a much higher magnification. The surface of the kidney is a capsule consisting of two distinct layers of connective tissue. The outer layer is typical collagen fibres and fibroblasts (each with a very thin, elongated nucleus). The inner layer is more cellular as it is occupied by many myofibroblasts each with an elonged but paler nucleus. The functional significance of these myofibroblasts is unknown. Within the hilum of the kidney this capsule becomes continuous with the connective tissue linings of the calyces and the renal pelvis. Just under the capsule you can identify a number of profiles of proximal convoluted tubules.


The kidney cortex is the outer (darker and pink stained) region covered by the capsule you viewed in the earlier item. A slightly increased magnification here reveals each renal corpuscle and cross sections of the nephron tubules. A series of vertical striations - the medullary ray (detailed in a later item) are straight tubules of the nephron and collecting ducts that extend to the medulla and divide the cortex into cortical labyrinth containing each renal corpuscle, convoluted tubules of the nephron and the collecting tubules and define the axis of the kidney "lobule". The concept of the kidney "lobule" (described in a later item) is important to understand.


The structure of the nephron in this atlas will be based on cortical nephrons. Each of these nephrons has its renal corpuscle located just under the capsule or in the outer cortex. Their loops of Henle extend only to the edge of the outer medulla.


As the name suggests these nephrons are located in the middle region of the cortex labyrinth - that region between medullary rays (i.e. straight tubules of the nephron and collecting ducts) containing the renal corpuscle, convouted and collecting tubules of each nephron.


Each juxtamedullary nephron has its renal corpuscle located near the base of the medullary pyramid. These nephrons make up less that about 10% of all nephrons but their structural peculiarities are important for their urine concentrating role.


A renal corpuscle is located in the cortex and is the specialised structure where filtration occurs. Each is an aggregation of capillaries enclosed within a cup-shaped capsule called the glomerular (Bowman’s) capsule. Identify red blood cells within these capillaries. The capsule has an outer (parietal) surface layer of squamous epithelial cells and the inner (visceral) layer invests the glomerular capillaries.
The space between the glomerular capillaries and the parietal layer of Bowman’s capsule is referred to as the capsular or urinary space. This space receives plasma fluid that filters through the glomerular capillaries and the visceral layer of epithelial cells called podocytes.
In this H&E section, podocytes are difficult to distinguish from other populations of cells present (e.g. mesangial cells) but assume if you identify a cell nucleus on the periphery of the glomerulus that is larger and more spherical then it is probably a podocyte rather than a flattened nucleus belonging to an endothelial cell. You will see this distinction better when you view the renal corpscule where the basement membrane has been specifically stained and podocytes are definitely outside surface of the basement membrane of the capillary wall.


Interlobular arteries give off tiny afferent arterioles which run into the lobule to supply each renal corpuscle. An afferent arteriole enters a renal corpuscle, breaks up into a tuft of capillaries called a glomerulus, and then collects back into an efferent arteriole instead of a vein. This occurs at the "vascular pole". This is a nice image because it also shows part of a glomerulus with the urinary (tubular) pole visible (see more details in the next item). You may see an arteriole, but it will be impossible to tell whether it is afferent or efferent (although there is a slight hint that it is an afferent arteriole because it is adjacent to a distal convoluted tubule - ignore this though for now!). The efferent arteriole runs for only a short distance before breaking up into a second bed of peritubular capillaries, which nourish the proximal and distal tubules and absorb fluid. Even when these capillaries are collapsed you can easily see abundant red blood cells within their lumens between the convoluted tubules.


Besides the vascular pole (where the afferent and efferent arteriole enters or leaves the glomerulus; see previous item) each renal corpuscle has a urinary (tubular pole) where the proximal convoluted tubule originates. Note that the simple squamous epithelium of the parietal layer of the glomerulus (Bowman's) capsule abruptly changes to a simple cuboidal epithelium in the proximal convoluted tubule.


The PASH stain emphasizes the basement membranes which are particularly prominent in the kidney. The cells themselves have a very washed out appearance but the entire organization of the kidney is graphically outlined by basement membranes. Remember, "PAS" stains carbohydrates magenta and "H" refers to the familiar "Hematoxylin".
Note the extensive crimson staining of the basement membranes of a glomerulus. You should be aware of the importance of the basement membrane to renal function. With this membrane so well stained it is just possible to recognize some podocytes as lying on the outside of it (see also the next item). In most H&E preparations it is impossible to distinguish them from the endothelial cells lying under the basement membrane.
The entire nephron is surrounded by a very well developed basement membrane supporting the squamous epithelial cells comprising the parietal layer of the glomerular (Bowman's) capsule.


With the basement membranes so well stained it is just possible to recognize a nucleus of a podocyte lying on the outside of it. Can you identify more of these cells? In most H&E preparations it is impossible to distinguish them from the endothelial cells lying under the basement membrane. Recall that together with capillary endothelial cells of the glomerulus (and the basement membranes) the podocytes form the filtration structure.


Recall that the proximal convoluted tubule (PCT) originates from the urinary pole as it is the tubule receiving the glomerular filtrate. You can see many profiles of the PCT in this image because it is very tortuous alongside the glomerulus and then will enter a medullary ray as a proximal straight tubule. The cuboidal cells of the PCT have central nuclei and are specialised for absorption and fluid transport so they have many specializations at the ultrastructural level to reflects these functions. For example, their intensely acidophilic cytoplasm reflects abundant mitochondria and they exhibit a "brush border" at their apices and evidence of this is provided in the next item. The lumenal border is rather convoluted and the total diameter of the tubule is greater than that of a distal convoluted tubule. Note the tiny blood capillary surrounding a PCT.


The tall brush border of each proximal convoluted tubule are rich in glycocalyx and therefore, carbohydrate. You may have looked at the brush border during your study of "epithelium" and noted that the brush border is comprised of numerous microvilli extending from the apical surface of the cells.


The distal convoluted tubule (DCT) is a continuation of the distal straight tubule (thick ascending limb of the loop of Henle). The DCT tubule is much less tortuous than the proximal convoluted tubule so you see less profiles of sections of these in the cortical labyrinth. The fluid in the DCT passes into a collecting tubule which in turn empties the fluid into a collecting duct in the medullary ray.


The distal straight tubule traverses the medulla into the cortex within a medullary ray and aligns itself adjacent to the vascular pole of the renal corpuscle with which it is a component. A clustering of nuclei of epithelial cells lining the distal straight tubule directly adjacent to the afferent arteriole in the vicinity of the vascular pole of the renal corpuscle form the "macula densa".
Again make sure you can identify a glomerulus and the simple squamous epithelium of the parietal layer of Bowman's capsule, lining the urinary space.
You probably will not be able to properly recognize the juxtaglomerular cells of the afferent arteriole and I am only assuming they are what is labelled and that the vessel is the afferent arteriole.


Collecting tubules traverse the cortical labyrinth only a short distance and then join collecting ducts in medullary rays. Their epithelial lining can be simple cuboidal or simple squamous in shape but they are easily distinguished from proximal convoluted tubules and distal convoluted tubules by visible cell boundaries between adjacent epithelial cells.


In the middle of each renal lobule are descending and ascending limbs of the nephron and a collecting duct. Collections of straight tubules and collecting ducts form the medullary ray within the cortex. The renal lobule is a cortical structure and nephrons in the same lobule drain into the collecting duct. Each interlobular artery branches into a number of afferent arterioles which each form a glomerulus, a capillary network and the efferent arteriole.
So, a renal lobule can be defined in two ways:
Firstly, the portion of the cortex contained within two adjacent interlobular arteries. e.g. interlobular artery (X) and (Y).
Secondly, it consists of a single collecting duct and the nephrons that drain into it. A medullary ray (Z) forms the axis of a renal lobule.


In most stained sections of kidney (including H&E), the medulla is the lighter stained inner region of the kidney. It contains straight tubules and collecting ducts with associated blood capillaries - the vasa recta. These tubules form conical shaped renal pyramids - their base faces the cortex and the apices open into a minor calyx through the tip of each pyramid (renal papilla). Pyramids are separated by extensions of the cortex (renal columns).


When compared with long proximal convoluted tubules, the proximal straight tubule (or thick descending limb of the loop of Henle) is only short and does not have a well developed brush border (they are not as specialized for absorption).


Based on electron microscopic investigations there may be as many as four different epithelial cells that line thin segments (thin descending or thin ascending loops of Henle) but they are too hard to distinguish in this light microscope image as they are very small with a simple squamous epithelium - although there are a few with what appears to be a simple cuboidal epithelium.
Profiles of proximal straight tubules (with not as well developed brush borders as the proximal convoluted tubules) and the lighter stained distal straight tubules can be seen here cut in cross section.


Cuboidal epithelium of the distal straight tubule (thick ascending limb of the loop of Henle) stain lightly compared to the intensely eosinophilic stained epithelial cells of a proximal straight tubule.


Each collecting duct is easily distinguished from other tubules e.g. a proximal straight tubule because you can see very distinct boundaries between the cuboidal epithelial cells - each having a centrally located nucleus.

Vasa recta are collections of descending arterioles and ascending venules in the medulla and function as countercurrent exchangers. They can be identified by the red blood cells within their lumens.


A medullary ray is visible as striations running from the medulla to the cortex. Each medullary ray is a collection of straight tubules and collecting ducts. They are cortical structures.
Review this diagram outlining the kidney vasculature. In histological sections you really only see the interlobular arteries and veins and maybe the arcuate arteries and veins.


Each small interlobular artery (sometimes referred to as a "cortical radial artery") originates from the arcuate artery and then travels through the cortical labyrinth (containing the more eosinophilic proximal and the paler stained distal convoluted tubules) between adjacent medullary rays towards the kidney capsule. Some reach as far as the capsule and supply this outer covering of the kidney. An afferent arteriole supplying each glomerulus arises along the path of this interlobular artery or a number may arise from a common branch from the interlobular artery. I think there is an afferent arteriole supplying the glomerulus partly visible in this image because nearby is a macula densa in the wall of a distal straight tubule.


Tiny peritubular capillaries (you can see red blood cells within their lumens) are a continuation of the efferent arteriole exiting the glomerulus in the upper and middle cortex and are associated with tubules within the cortical labyrinth. Peritubular capillaries empty into an interlobular vein. In contrast, efferent arterioles exiting juxtamedullary glomeruli gives rise to vasa recta in the medulla.


Interlobar arteries originate from a segmental artery branching from the renal artery within the renal sinus. The arcuate artery arises from an interlobar artery in each renal column then travels (an arched path) along the base of each pyramid between the medulla and the cortex. The arcuate vein, having received blood from interlobular veins and the vasa recta, empty blood into the interlobar vein and then the renal vein.


A renal pyramid is a conical structure in the medulla formed by the tubules. Humans may have 8-12 pyramids. The base of the pyramid faces the cortex and the apex (papilla) projects into the minor calyx


The renal papilla is the tip of each pyramid. The indented epithelial surface at the tip of the papilla (area cribosa) may represent the merging of collecting ducts to form a papillary duct (duct of Bellini) that empties urine into the minor calyx. The collecting ducts are wider in diameter and will exhibit epithelium with increasing numbers of columnar cells.


At low magnification, observe the three layers of the ureter: mucosa, muscularis and adventitia. This organization is maintained throughout the urinary passages. The mucosa of the ureter is thrown into characteristic longitudinal folds. It is made of transitional epithelium underlain by a layer of fairly cellular connective tissue (lamina propria). Quite a few lymphocytes are found in this lamina propria. The muscularis layer consists of two somewhat diffuse sheets of smooth muscle: the inner is longitudinal, and the outer is circular. Towards the bladder end it picks up a third oblique layer. This muscle produces peristaltic waves that push the urine to the bladder even when you are lying down. The adventitia is made of connective tissue and contains the nerves and blood vessels that supply the organ. One thing to note is that the ureter runs through loose connective tissue from the kidney to the bladder.


The ureter and also the other passages within the kidney through which urine flows i.e. the calyces and renal pelvis, are lined by transitional epithelium (often referred to as urothelium). The details of the layers of cells within this type of epithelium is best described in the later item "lumenal epithelium" of the bladder but generally it is 2-3 cell layers thick in the minor calyces but much thicker as you see here in the ureter and then the bladder.


Connective tissue and smooth muscle make up the remainder of the wall of the ureter. The smooth muscle is in longitudinal and circular layers so when you examine the section see if you can pick out these longitudinal and circular layers of muscle.


The layers of the bladder are basically the same as in the ureter. However, the muscle layer is much thicker and includes a third sheet of smooth muscle with oblique orientation. Of course for a spherical organ like the bladder "longitudinal", "circular", and "oblique" are somewhat formalistic terms. In any case, sheets of smooth muscle running in different orientations are discernable although somewhat indistinct. The smooth muscle became “super contracted” when put in fixative. This has thrown the mucosa into pronounced folds. The epithelium also is over contracted in places. When you view this histological section find some nice views of rounded up umbrella cells with their acidophilic apical borders. Look further and you will come across patches of transitional epithelium in a relaxed state.


All the excretory passages (apart from the urethra) have a mucosa with transitional epithelium and muscularis and an outer adventitia.


Transitional epithelium is impermeable to water and salts and can accomodate the distension of the bladder as it fills with urine. In this image of "relaxed bladder" there are about 8 cell layers but make sure you notice how these layers "flatten out" in the "stretched bladder" image in the later item. Notice how the surface cells are cuboidal and bulge into the lumen of the bladder but their apex is curved or shaped like a dome so they are often referred to as "umbrella cells". The connective tissue below the epithelium is very cellular.


Even at the light microscope level, careful examination of the apical plasma membrane of an umbrella cell reveals a slightly thicker/denser area called plaques. In a relaxed bladder many plaques have invaginated into the cell and so the contour of the epithelial surface appears "scalloped".


When the lumenal epithelium of the bladder is distended (stretched) the cell layers are reduced as the cells flatten and unfold as the lumenal surface area increases. The surface cells that were once a cuboidal cell undergo a "transition" to become a squamous cell. Compared to the relaxed bladder this epithelium has a less "scalloped" appearance as the "plaques" position themselves on the apical cell surface.


You will study the penis in more detail in the topic "Male reproductive system" so only the urethra concerns us at the moment. Locate this structure in the spongy portion (corpus spongiosum) of erectile tissue.


The lining of the penile (spongy) urethra is stratified or pseudostratified columnar epithelium with patches of stratified squamous epithelium. As the urethra broadens to its terminal enlargement and opens at the apex of the penis, the epithelium becomes predominantly stratified squamous in form. Notice the epithelial outpocketings for mucus secreting urethral glands, called the "glands of Littre" . These are actually easier to distinguish than paraurethral glands in the female urethra. The names of these urethral glands are unimportant. In fact, the glands themselves probably are not very important. They just provide a bit of protection to the non-transitional epithelium that is exposed to harsh urine.


Locate the urethra lumen. The three layers of the ureter are repeated, but they are thicker and the muscle layers are not as distinct as you will see when you view this section. I think the muscle in this part of the female urethra is smooth muscle. I can't see any skeletal muscle which would indicate this was the middle part of the female urethra.


The mucosa has longitudinal folds which you may now appreciate better if you relook at the low magnification image in the previous item. The epithelium of the urethra will vary according to the region from which a section is taken. In this image, taken near the bladder, it is urinary/transitional epithelium (urothelium), at the external opening it is stratified squamous epithelium, and between those two ends the epithelium is pseudostratified or stratified columnar.


Small outpocketings of mucus-secreting cells form clusters in the epithelium and extend into the lamina propria as simple paraurethral glands. Those located within the epithelial layer are examples of intra-epithelial glands.